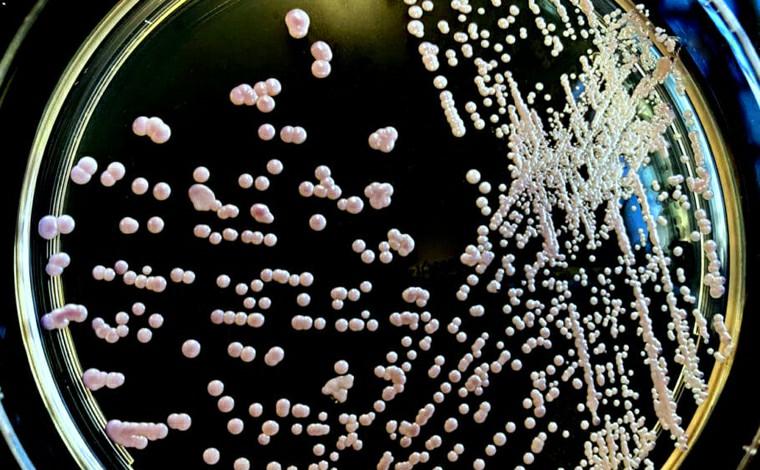

A Agência Nacional de Vigilância Sanitária (Anvisa) emitiu um alerta epidemiológico nesta semana, depois da suspeita do primeiro caso de um superfungo fatal no Brasil, o Candida auris (C. auris). Por ser resistente a medicamento e por não ser identificável através de métodos tradicionais, o fungo se tornou um dos mais temidos do mundo e pode levar à morte de 30% a 60% dos infectados.
No Brasil, não havia relato de nenhum caso de infecção pelo fungo, mas nesta segunda-feira (7) foi notificado um possível primeiro caso positivo em paciente internado na UTI em um hospital do estado da Bahia. O fungo foi identificado após análise realizada em dois laboratórios.
Por ser uma grave ameaça à saúde global, os serviços de saúde e laboratórios de microbiologia devem seguir as orientações previstas no Comunicado de Risco, para adotar as ações de prevenção e controle da disseminação desse fungo no país.
Segundo a Anvisa, a maior preocupação com o C. auris seria a sua alta resistência. Ele sobrevive em superfícies durante um longo período e pode também ser transmitido de pessoa para pessoa. Apenas produtos de limpeza hospitalar são capazes de elimina-lo.
O fungo emergente foi identificado pela primeira vez como causador de doença em humanos em 2009, no Japão.
Da Redação
Sete Lagoas Notícias